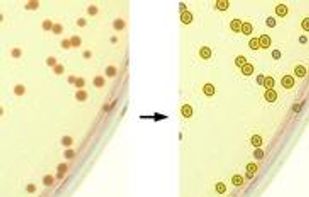
OpenCFU screenshot 2

Cost / License
- Free
- Open Source (MIT)
Platforms
- Self-Hosted


OpenCFU is a completely open source lightweight application designed to enumerate clustered circular objects such as bacterial colonies. It can handle digital pictures as well as live stream from a video device/webcam.